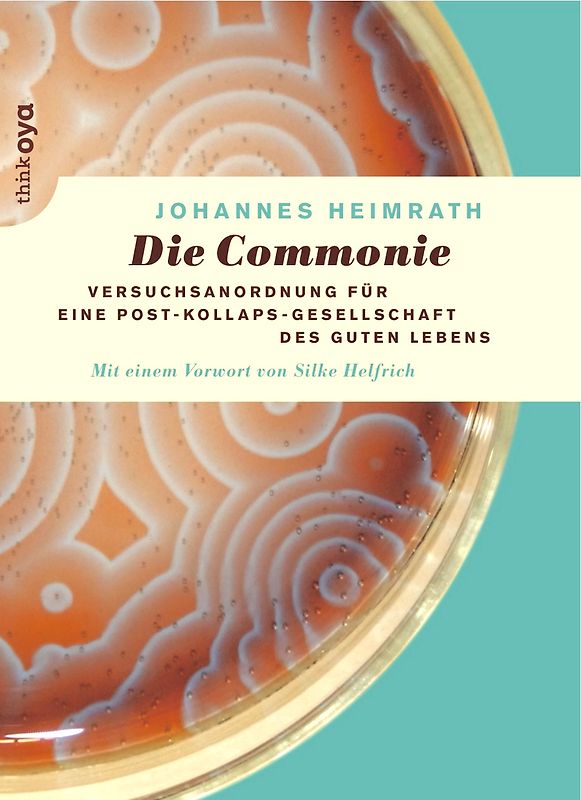
Die Commonie

iPhoneAlle anzeigen
iPhone 11iPhone 11 ProiPhone 11 Pro MaxiPhone 12iPhone 12 ProiPhone 12 Pro MaxiPhone 12 miniiPhone 13iPhone 13 ProiPhone 13 Pro MaxiPhone 13 miniiPhone 14iPhone 14 PlusiPhone 14 ProiPhone 14 Pro MaxiPhone 15iPhone 15 PlusiPhone 15 ProiPhone 15 Pro MaxiPhone 16iPhone 16 PlusiPhone 16 ProiPhone 16 Pro MaxiPhone 16eiPhone 8iPhone 8 PlusiPhone SE 2020iPhone SE 2022iPhone XiPhone XRiPhone XSiPhone XS Max
Galaxy A-SerieAlle anzeigen
Galaxy A12Galaxy A13Galaxy A13 5GGalaxy A14Galaxy A15Galaxy A16Galaxy A17 5GGalaxy A20eGalaxy A21Galaxy A22Galaxy A23Galaxy A24Galaxy A25Galaxy A26 5GGalaxy A32Galaxy A33Galaxy A34Galaxy A35Galaxy A36 5GGalaxy A40Galaxy A41Galaxy A42Galaxy A50Galaxy A51Galaxy A52Galaxy A53Galaxy A54Galaxy A55Galaxy A56 5GGalaxy A70Galaxy A71Galaxy A72
Redmi SeriesAlle anzeigen
Redmi 10Redmi 13CRedmi 15 5GRedmi Note 10Redmi Note 10 ProRedmi Note 11Redmi Note 11 ProRedmi Note 11 Pro Plus 5GRedmi Note 11sRedmi Note 12Redmi Note 12 5GRedmi Note 12 ProRedmi Note 12 Pro 5GRedmi Note 12 Pro PlusRedmi Note 13Redmi Note 13 5GRedmi Note 13 ProRedmi Note 13 Pro PlusRedmi Note 14Redmi Note 14 Pro PlusRedmi Note 8Redmi Note 8 ProRedmi Note 9Redmi Note 9 Pro
Derzeit nicht verfügbar
Handgeprüfte Gebrauchtware
Bis zu 50 % günstiger als neu
Der Umwelt zuliebe
Optischer Zustand
Beschreibung
'Die Frage ist nicht mehr, ob der Zusammenbruch kommt sondern wie wir danach leben werden', schrieb Johannes Heimrath in seinem letzten Buch 'Die Post-Kollaps-Gesellschaft'. Hier nun entwickelt der Autor seine positive Vision für die Zeit 'danach' in gebührender Tiefe. Eine Post-Kollaps-Gesellschaft des guten Lebens wird aus Commonien bestehen, schreibt Heimrath, selbst ein Pionier… gemeinschaftlicher Lebensmodelle. Die Commonie (von engl. 'commons', Gemeingüter) ist das Modell einer Allmende-Gesellschaft, das Wege in eine wirklich nachhaltige und gerechte Zukunft weist. Die Commonie unterscheidet sich radikal von unseren gegenwärtigen von Konkurrenz und Ausbeutung geprägten Waren- und Konsumgesellschaften: Sie basiert auf der Ökonomie der Gabe, auf Konsensentscheidungen und auf dem symbiotischen Miteinander des Menschen und seiner Mitwelt. Im Sinn einer Versuchsanordnung fragt Heimrath: Was braucht ein gutes Leben? Wie müssen wir leben, um vom Schädling zum Nützling der Erde zu werden? Wie sieht eine Gesellschaft aus, in der nichts irgendjemandes Eigentum, sondern alles sich selbst zueigen ist? Im Dialog mit Vordenkerinnen und Vordenkern der Commons-Bewegung zeichnet der Autor einen ermutigenden, visionären und ganz und gar bodenständigen Entwurf für eine künftige enkeltaugliche Gesellschaft, in der die Fülle des Lebens als Ganze, nicht der Profit Einzelner im Mittelpunkt steht. Dabei betont Heimrath: Es gibt keine Patentrezepte Commonien sind so eigen und individuell wie ihre Menschen und Orte. Und: Commonien sind keine Utopie – es gibt sie bereits heute. Dieses Produkt haben wir gerade leider nicht auf Lager.
Handgeprüfte Gebrauchtware
Bis zu 50 % günstiger als neu
Der Umwelt zuliebe
Technische Daten
Erscheinungsdatum
01.11.2016
Sprache
Deutsch
EAN
9783927369733
Herausgeber
thinkOya
Sonderedition
Nein
Autor
Johannes Heimrath
Seitenanzahl
200
Auflage
1
Einbandart
Broschiert
Einbandart Details
Fadenbindung
-.-
★★★★★
☆☆☆☆☆ Leider noch keine Bewertungen
Leider noch keine Bewertungen
Sicher bei rebuy kaufen
Schreib die erste Bewertung für dieses Produkt!
Wenn du eine Bewertung für dieses Produkt schreibst, hilfst du allen Kund:innen, die noch überlegen, ob sie das Produkt kaufen wollen. Vielen Dank, dass du mitmachst!
Sicher bei rebuy kaufen
